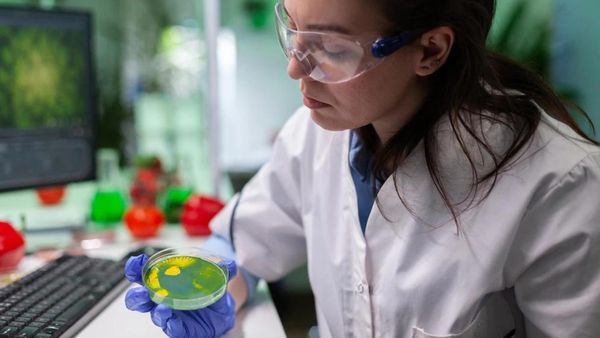
WHO Publishes First-Ever List Of Fungal Pathogens: What You Should Know WHO Publishes First-Ever List Of Fungal Pathogens: What You Should Know

Latest Updates
-
 A Hotel on Wheels: Bihar Rolls Out Its First Luxury Caravan Buses
A Hotel on Wheels: Bihar Rolls Out Its First Luxury Caravan Buses -
 Bharti Singh-Haarsh Limbachiyaa Welcome Second Child, Gender: Couple Welcome Their Second Baby, Duo Overjoyed - Report | Bharti Singh Gives Birth To Second Baby Boy | Gender Of Bharti Singh Haarsh Limbachiyaa Second Baby
Bharti Singh-Haarsh Limbachiyaa Welcome Second Child, Gender: Couple Welcome Their Second Baby, Duo Overjoyed - Report | Bharti Singh Gives Birth To Second Baby Boy | Gender Of Bharti Singh Haarsh Limbachiyaa Second Baby -
 Bharti Singh Welcomes Second Son: Joyous News for the Comedian and Her Family
Bharti Singh Welcomes Second Son: Joyous News for the Comedian and Her Family -
 Gold & Silver Rates Today in India: 22K, 24K, 18K & MCX Prices Fall After Continuous Rally; Check Latest Gold Rates in Chennai, Mumbai, Bangalore, Hyderabad, Ahmedabad & Other Cities on 19 December
Gold & Silver Rates Today in India: 22K, 24K, 18K & MCX Prices Fall After Continuous Rally; Check Latest Gold Rates in Chennai, Mumbai, Bangalore, Hyderabad, Ahmedabad & Other Cities on 19 December -
 Nick Jonas Dancing to Dhurandhar’s “Shararat” Song Goes Viral
Nick Jonas Dancing to Dhurandhar’s “Shararat” Song Goes Viral -
 From Consciousness To Cosmos: Understanding Reality Through The Vedic Lens
From Consciousness To Cosmos: Understanding Reality Through The Vedic Lens -
 The Sunscreen Confusion: Expert Explains How to Choose What Actually Works in Indian Weather
The Sunscreen Confusion: Expert Explains How to Choose What Actually Works in Indian Weather -
 On Goa Liberation Day 2025, A Look At How Freedom Shaped Goa Into A Celebrity-Favourite Retreat
On Goa Liberation Day 2025, A Look At How Freedom Shaped Goa Into A Celebrity-Favourite Retreat -
 Daily Horoscope, Dec 19, 2025: Libra to Pisces; Astrological Prediction for all Zodiac Signs
Daily Horoscope, Dec 19, 2025: Libra to Pisces; Astrological Prediction for all Zodiac Signs -
 Paush Amavasya 2025: Do These Most Powerful Rituals For Closure On The Final Amavasya Of The Year
Paush Amavasya 2025: Do These Most Powerful Rituals For Closure On The Final Amavasya Of The Year
WHO Publishes First-Ever List Of Fungal Pathogens: What You Should Know
The World Health Organization has compiled the first-ever list of fungal pathogens posing the greatest threat to human health, warning that some strains are becoming increasingly drug-resistant and more common [1].
According to the United Nations, fungal infections are on the rise and are becoming increasingly resistant to treatment. Similar lists are also available for viruses and bacteria. The lack of attention paid to the danger in the past has caused huge gaps in knowledge and a lack of surveillance, treatments, and diagnostics [2].
"Emerging from the shadows of the bacterial antimicrobial resistance pandemic, fungal infections are growing, and are ever more resistant to treatments, becoming a public health concern worldwide", said Dr Hanan Balkhy, WHO Assistant Director-General, Antimicrobial Resistance (AMR) [3].

Here are the important points:
1. According to the WHO, the Fungal Priority Pathogens List (FPPL) is the first global effort to systematically prioritise fungal pathogens, given the unmet research and development (R&D) needs and perceived importance of these pathogens for public health.
2. A growing body of evidence indicates that fungal diseases are becoming more prevalent worldwide as a result of global warming, as well as an increase in international travel and trade.
3. During the COVID-19 pandemic, invasive fungal infections have increased significantly among hospitalised patients.
4. Experts ranked fungal pathogens based on the fungus's impact on public health and how much research and development it has received.
There are three priority categories on the WHO FPPL list: critical, medium and high.
- The critical group of bacteria includes Candida auris, which is highly drug-resistant and has caused several outbreaks in hospitals around the world, as well as Cryptococcus neoformans, Aspergillus fumigatus, and Candida albicans.
- The medium group contains several other fungi, including Coccidioides spp. and Cryptococcus gattii [4].
- The high group includes several other fungi from the Candida family as well as others such as Mucorales, a group which contains the fungi that cause mucormycosis, or "black fungus," a severe infection which spreads rapidly among seriously ill individuals - particularly in India - during COVID-19.
The Risk of Fungal Infections
People can get sick from fungi, although there is only a small number that are capable of causing illness. Moulds, yeasts, and mushrooms belong to the fungus family [5].
Fungi can cause many types of illnesses, such as:
- Asthma or allergies
- Rashes or infections on the skin and nails
- Lung infections (pneumonia) with symptoms similar to the flu or tuberculosis
- Bloodstream infections
- Meningitis
Who Is At Risk Of Fungal Infections?
Even healthy individuals are vulnerable to fungal infections. This is because fungi are commonly found in the environment, and people are exposed to fungal spores every day without getting sick. However, people with weakened immune systems are more likely to become infected by these fungi [6].
Several fungal infections, such as skin, nail, and vaginal yeast infections, are not harmful to the body. However, some infections are more serious, such as Valley fever or histoplasmosis, which are likely to occur in certain areas where people live or visit.
How To Prevent Fungal Infections?
A fungal infection can be uncomfortable or even painful. In some situations, they may require weeks or months to treat effectively. If you suspect that you may have a fungal infection, see your doctor. They will diagnose the type of infection and prescribe an appropriate antifungal medication. To avoid fungal infections, it is also important to maintain good hygiene [7][8].
On A Final Note...
Experts believe that with the Fungal Priority Pathogen List release, policymakers should now have guidelines in place to assist them in identifying the invasive fungal pathogens of greatest priority.
Disclaimer: The information provided in this article is for general informational and educational purposes only and is not intended as a substitute for professional medical advice, diagnosis, or treatment. Always seek the advice of your physician or a qualified healthcare provider with any questions you may have regarding a medical condition.



 Click it and Unblock the Notifications
Click it and Unblock the Notifications












